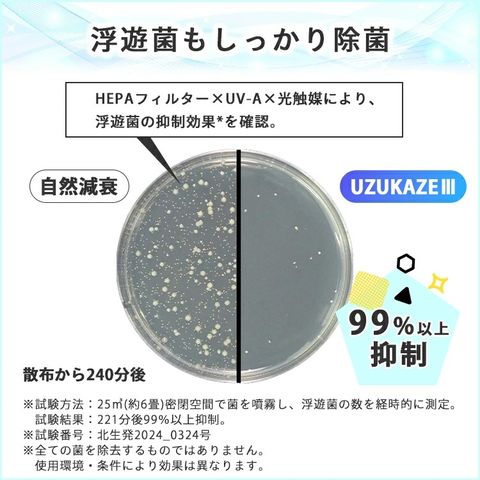

6/7
時点_ポイント最大19倍
シーリングファンライト UZUKAZE3 FCE-570【ホワイト】(ウズカゼ 天井照明 シーリングライト スワン電器 サーキュレーターライト 扇風機 羽根なしシーリングファンライト 脱臭)【送料無料】
カラー
-
ホワイト
-
ナチュラル
[在庫なし]
販売価格
29,700
円 (税込)
送料込み
- 出荷目安:
- 営業日14時迄の決済で即日出荷(欠品時除く)
たまるdポイント(通常) 270
+キャンペーンポイント(期間・用途限定) 最大18倍
※たまるdポイントはポイント支払を除く商品代金(税抜)の1%です。
※表示倍率は各キャンペーンの適用条件を全て満たした場合の最大倍率です。
各キャンペーンの適用状況によっては、ポイントの進呈数・付与倍率が最大倍率より少なくなる場合がございます。
dカードでお支払ならポイント3倍
各キャンペーンの適用状況によっては、ポイントの進呈数・付与倍率が最大倍率より少なくなる場合がございます。
※クーポン適用後の費用は決済画面で確認できます
- 商品情報
- レビュー
【正規販売店】空気を清浄・脱臭・循環!羽なし設計&HEPA×UV-Aで快適空間を実現する次世代シーリングファン















■keyword:空気清浄機付きシーリングライト/脱臭機能付きシーリングライト/照明付きシーリングファン/LEDシーリングライト/高機能シーリングライト/おしゃれシーリングライト/モダンシーリングライト/リビング/寝室/子供部屋/ダイニング/キッチン/脱臭/除菌/空気清浄/空気循環/サーキュレーター/HEPAフィルター/UV-A/光触媒/Matter対応/スマートホーム/スマート家電/調光/調色/10段階調光/20段階調色/大風量/省エネ/薄型/天井照明/ライト/ファン/空気清浄器/脱臭機/ウズカゼ/ウズカゼ3/FCE570/ホワイト/White/WH/ナチュラル/Natural/NT/白/木目調/生活臭/ペット臭/花粉対策/PM2.5対策/ウイルス対策/浮遊菌対策/静音設計/リモコン付き/簡単取付/最大14畳対応/5500lm/シーリングライト14畳/LEDシーリングライト14畳/空気清浄機14畳/脱臭機14畳/お祝い/誕プレ/誕生日プレゼント/バースデー/クリスマスプレゼント/バレンタインデー/ホワイトデー/返礼品/お返し/サプライズ/記念日/友人/友達/友だち/新生活/入籍祝い/結婚祝い/新築祝い/内祝い/引っ越し祝い/引越し祝い/引越祝い/転居祝い/社会人/母の日/父の日/敬老の日/還暦祝い/10代/20代/30代/40代/50代/60代/70代/女性/男性

| 空気清浄もできる次世代シーリングファンライト |
|
人気の「UZUKAZE」シリーズがさらに進化。 羽のない安心設計で、風をお部屋全体にやさしく循環させながら、空気の除菌・脱臭・清浄を同時に実現。 新搭載のUV-A×光触媒と大型HEPAフィルターで、生活臭やペットのニオイ、浮遊菌をパワフルに対策。 LED照明も高性能で、明るく快適な空間をつくります。 スマートホーム規格「matter」にも対応した、最新モデルです。 |

| 高性能フィルターと静音設計で、空気も照明も美しく |
|
・UV-A×光触媒で気になるニオイをしっかり分解 ・浮遊菌を抑制する空気清浄機能がさらに強化 ・斜めに吹き出す風で効率よく部屋全体に空気を循環 ・シリーズ最大サイズのHEPAフィルターを搭載 ・調光・調色も自由自在な高性能LEDライト ・スマートホーム連携OKな「matter」対応モデル |









| サイズ・詳細 |


| バリエーション |
|
ホワイト、ナチュラル からお選びください。 |


| 商品名 | UZUKAZE3 FCE-570 |
| メーカー・ブランド | スワン電器 |
| 自社品番 | ホワイト(SWDK-FCE-570WH) ナチュラル(SWDK-FCE-570NA) |
| セット内容・構成品 | ・器具本体 ・フロントカバー ・アダプタ ・リモコン ・取扱説明書 ・単4電池(確認用電池)×2本 |
| サイズ(約) | 幅530mm×奥行き530mm×高さ100mm |
| 素材・成分 | 樹脂・アルミ・スチール |
| 重量(約) | 3.7kg |
| 仕様 | ・消費電力(最大):58W ・器具光束:5500lm ・定格寿命:40000h ・色温度:3,000?6,500K ・演色性:Ra80 ・消費効率:131lm/w |
| 製品保証 | 1年 |
| 広告文責 | エルスタイル(株) |
| 注意事項 | |
|
※表示された電源電圧(AC100V),周波数(50/60Hz)以外で使用しな いでください。 ※本製品をご使用中に、ラジオ等の音響機器への雑音や、他の家電製品の赤外線リモコンが作動しない場合がごくまれにあります。この場合、トラブルが発生しなくなる距離まで離してご使用ください。 ※調光器(ライトコントロール)との併用は出来ません。チラツキ、立ち消え等の点灯不良や調光器、照明器具の故障の原因になります。 ※この器具は天井取付専用器具です。天井面が平らであることをお確かめください。下記のような天井に取り付けますと器具がガタついたり、簡単に回転して取り付けが不十分となり、火災・感電・落下の原因となります。 【取付禁止天井】 船底天井・格子天井・竿縁天井・傾斜天井・その他に凹凸のある天井には取り付けないでください。 ※適合する配線器具を確認してください。付いていない場合は、工事店・電気店に依頼して取り付けてください。配線器具などの取付工事は、電気工事有資格者による施工が義務付けられています。 ※商品の色はモニターの具合で実物と若干異なる場合がございます。予めご了承下さい。 ※デザイン、仕様等につきましては、予告なく変更する場合がございます。予めご了承下さい。 ※ご予約・お取り寄せ商品は、ご注文受付後にお客様ご注文分としてメーカーへ発注を致します為、基本的にキャンセルやご返品はお受けできません。 ※複数店舗を運営しておりますため、ご注文の入れ違い等で欠品などになってしまう場合がございます。万が一、発送が遅れる場合は、ご注文受付当日中にご案内差し上げます。誠に恐れ入りますがご了承くださいますよう、お願い申し上げます。 | |
■keyword:空気清浄機付きシーリングライト/脱臭機能付きシーリングライト/照明付きシーリングファン/LEDシーリングライト/高機能シーリングライト/おしゃれシーリングライト/モダンシーリングライト/リビング/寝室/子供部屋/ダイニング/キッチン/脱臭/除菌/空気清浄/空気循環/サーキュレーター/HEPAフィルター/UV-A/光触媒/Matter対応/スマートホーム/スマート家電/調光/調色/10段階調光/20段階調色/大風量/省エネ/薄型/天井照明/ライト/ファン/空気清浄器/脱臭機/ウズカゼ/ウズカゼ3/FCE570/ホワイト/White/WH/ナチュラル/Natural/NT/白/木目調/生活臭/ペット臭/花粉対策/PM2.5対策/ウイルス対策/浮遊菌対策/静音設計/リモコン付き/簡単取付/最大14畳対応/5500lm/シーリングライト14畳/LEDシーリングライト14畳/空気清浄機14畳/脱臭機14畳/お祝い/誕プレ/誕生日プレゼント/バースデー/クリスマスプレゼント/バレンタインデー/ホワイトデー/返礼品/お返し/サプライズ/記念日/友人/友達/友だち/新生活/入籍祝い/結婚祝い/新築祝い/内祝い/引っ越し祝い/引越し祝い/引越祝い/転居祝い/社会人/母の日/父の日/敬老の日/還暦祝い/10代/20代/30代/40代/50代/60代/70代/女性/男性